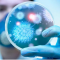

Թրամփը դատի է տվել Wall Street Journal թերթին

Միացյալ Նահանգների նախագահ Դոնալդ Թրամփը դատական հայց է ներկայացրել ամերիկյան Wall Street Journal թերթի սեփականատեր Ռուպերտ Մերդոքի և պարբերականի երկու լրագրողների դեմ։ Հայտնում է Ազատությունը։
ԱՄՆ նախագահը 10 միլիոն դոլարի փոխհատուցում է պահանջում մի հրապարակման համար, որում պնդում կար, թե 2003 թվականին Թրամփը Ջեֆրի Էփշտեյնին շնորհավորական նամակ է հղել: Դրանում, ըստ պարբերականի, մերկ կնոջ ձեռագիր պատկեր է եղել, իսկ տեքստում հիշատակում է եղել «ընդհանուր գաղտնիքների» մասին։ Թրամփը պնդում է,որ Wall Street Journal-ի հրապարակումը լուրջ վնաս է հասցրել իր գործարար համբավին։
Ջեֆրի Էփշտեյնը ամերիկացի ֆինանսիստ էր, որին մեղադրում էին անչափահասների սեքսուալ շահագործմանն ուղղված ցանց ստեղծելու համար։ 2019 թվականին այս մեղադրանքների հիման վրա Էփշտեյնը ձերբակալվել էր և դրանից քիչ անց ինքնասպան եղել բանտում։